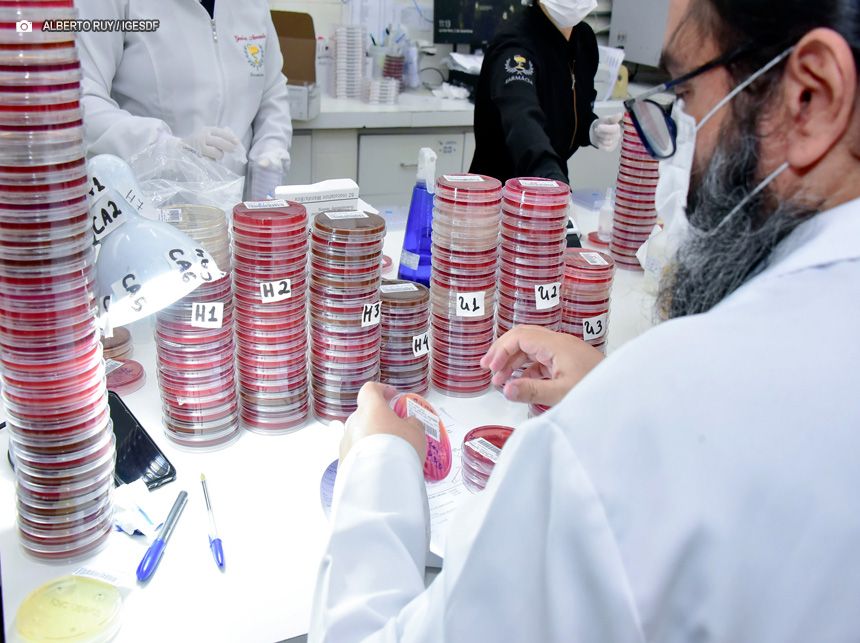
IGESDF abre processo seletivo para médico, farmacêutico e analista contábil

Desde 2018, a Companhia do Metropolitano do Distrito Federal (Metrô-DF) vem trabalhando na modernização do sistema de bilhetagem, com investimento em atualização tecnológica e aquisição de equipamentos, a fim de evitar a perda de arrecadação tarifária, possibilitar o seu correto controle, reduzir filas e facilitar a compra para os usuários do transporte público do Distrito Federal. O próximo passo é a aquisição de terminais de autoatendimento (ATMs).

Ainda não há prazo para a implantação, mas a Diretoria de Operação e Manutenção (DOM) já iniciou os estudos internos para mais esta etapa. “A automação de vendas de créditos permitirá a priorização das atividades de apoio e orientação ao usuário, bem como das atividades de gestão administrativa e operacional da companhia”, afirma o titular da DOM, Márcio Aquino.
Além disso, a racionalização das etapas de comercialização de créditos propiciará maior praticidade e acessibilidade ao usuário na aquisição do QR Code e na recarga de cartões do SBA (Sistema de Bilhetagem Automática), por meio de pagamento em espécie, cartão ou Pix.
A meta é instalar 63 máquinas nas 27 estações, contratando a locação dos equipamentos com operação assistida humanizada aos usuários, manutenção técnica, fornecimento de suprimentos e monitoramento de operação do sistema. O próximo passo é iniciar a elaboração do termo de referência e edital de licitação para a contratação.
Processo de modernização
Implementado em 2022, o sistema EMV permite pagamento por aproximação direta nos bloqueios das 27 estações de metrô
Até 2019, conviviam dois sistemas de bilhetagem no Metrô-DF: o Sistema de Bilhetagem Automática, que permitia a integração com o modal de ônibus por meio dos cartões, e o Sistema de Bilhetagem Eletrônica (SBE), com cartões smart card, bloqueios e equipamentos de venda (PDVs) específicos para tal sistema. Os dois sistemas não eram integrados, e ambos estavam sem manutenção.
Naquele ano, a companhia assinou o contrato com a fornecedora de tecnologia do SBA, tendo como objeto a locação de equipamentos e prestação de serviços de manutenção corretiva e preventiva de validadores, com fornecimento de peças, licenciamento e suporte técnico de software e demais condições necessárias de modo a viabilizar a operacionalização do sistema.
Com esse contrato ainda em vigência, o Metrô-DF conseguiu descontinuar o SBE e fazer a manutenção total do parque tecnológico, incluindo software e atualizações do SBA, além de ampliar e modernizar os bloqueios e os equipamentos de venda. Também foram adquiridos novos bloqueios de entrada, passando de 63 para 110, o que resultou no fim das filas e reclamações dos usuários no acesso das estações.
Foi ampliado de 67 para 69 o número de equipamentos de venda. Para viagens unitárias, o Metrô-DF passou a emitir QR Codes. Em 2022, em conjunto com a Secretaria de Transporte e Mobilidade (Semob-DF) e o BRB Mobilidade, operador do sistema de bilhetagem, o Metrô implantou o EMV, que permite o pagamento por aproximação diretamente nos bloqueios das 27 estações.
Desde então, o ingresso no sistema pode ser feito diretamente pelos bloqueios, aproximando cartões de crédito, débito, smartphones, smartwatches ou pulseiras de pagamento dos validadores instalados nas catracas de entrada. Nesse caso, o usuário não precisa mais se dirigir às bilheterias.